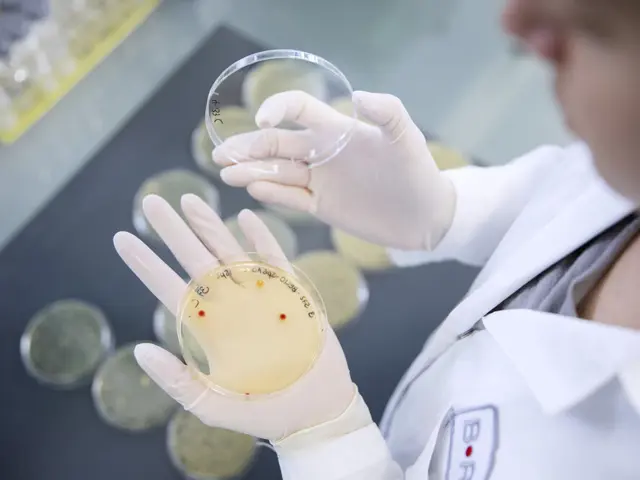

“There were blue skies and beautiful weather, with sunsets and sunrises I've never seen before.”
Ivar de Josselin de Jong, Director of Strategy & Commercial at Fugro, is remembering his time as a guest at this year’s Seabed Mapping and Inspection conference in Norway.
While the scenic winter landscape of ski resort town Geilo stuck out, he also appreciated how no time was wasted in getting down to the topic at hand.
“I arrived from Bergen, and was already meeting conference participants on the train. It was time well spent from the beginning till the very end.”
The conference, held by Tekna at Vestlia resort in Geilo, gathers key players – clients, suppliers, scientific institutions and authorities – every year. Whether you're charting the seabed for new installations or mining opportunities, or ensuring the integrity of existing installations, you can be sure to keep track of the latest developments here.
Speeding Up Uncrewed Surveying
When de Jong returns to the conference next year, it is to deliver the keynote address.
A geologist by education, de Jong came into this space through an offshore geophysics company he founded in the late 90s. From there, he connected with Geo-data leader Fugro, where he has worked for the last 17 years, gradually focusing more and more on the transformation of Fugro’s business from traditional crewed operations to remote operations with uncrewed surface vessels (USVs) and remotely operated vehicles (ROVs).
He arrives at the conference with a clear agenda – to speed up the uncrewed transformation of the field that is now within reach.
He says his address won't be a case of the industry patting itself on the back.
“We have achieved a lot, but we need to keep the momentum going. Right now, we are running into a variety of challenges, both regulatory as well as issues with organizational change and technology maturation.”
“Teaming Up is the Only Way”
This is felt across the industry. Conference organizer Chris Cooper is a hydrographer with Norwegian cable giant Nexans, and says there’s a real dilemma in picking between tried and tested solutions or stepping into the new world that de Jong and others are heralding in.
“The environmental savings can be massive, as can the safety benefits of not having people out at sea,” says Cooper.
“But it's not necessarily cheaper, and there are challenges with regards to rules and regulations.”
For de Jong, collaboration between stakeholders is an essential part of the message he is bringing to the conference.
“If we want to make this happen, we can't focus on being first over the finish line – we need to do this together. Teaming up is the only way to make that snowball rolling down the hill grow bigger.”
He hopes getting everyone under one roof in Geilo can create new connections between suppliers, authorities and clients – what he refers to as "the golden triangle".
“It’s by far the most effective conference I've seen in this space. Everyone's in the same hotel, we eat breakfast, lunch and dinner together. It’s a great opportunity to establish new relations or recalibrate existing relations.”
Three Days of Learning
Apart from de Jong's keynote, Cooper says the 2024 Geilo conference will provide learning points from operational experiences, as well as a look at future advances in the industry. He’s looking forward to three days of learning on a variety of subjects, ranging from innovative technologies to practical examples.
“A hot topic right now is unexploded ordnance buried under the seafloor – ammunition dumped into the sea. On the environmental side, there's also a paper on developments in technology for the monitoring of marine mammals.”
And in between presentations, de Jong urges conference participants to allow themselves a bit of fresh air as well.
“There's a three and a half hour lunch break, so you can go cross country skiing right outside the hotel door.”
Gain insight into what’s going on in the industry today and what the future will bring. Seabed Mapping and Inspection 2024 is three days with professionals learning from each other under the same roof, excellent for networking.